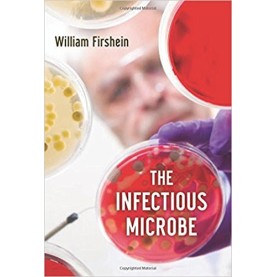
INFECTIOUS MICROBE C by FIRSHEIN - 9780199329618

SCHOOL EDUCATION-COMMERCE-ACCOUNTANCY
Industrial Organisation Markets and Strategies
Rs.1,165.50 Ex Tax: Rs.1,165.50
Industrial Organisation Markets and Strategies
Industrial Organisation Markets and Strategies..
Rs.1,165.50 Ex Tax: Rs.1,165.50
INFECTION & IMMUNITY 4E by PLAYFAIR & BANCROFT - 9780199609505
Rs.3,176.00 Ex Tax: Rs.3,176.00
INFECTION & IMMUNITY 4E by PLAYFAIR & BANCROFT - 9780199609505
INFECTION & IMMUNITY 4E..
Rs.3,176.00 Ex Tax: Rs.3,176.00
INFECTIOUS MICROBE C by FIRSHEIN - 9780199329618
Rs.2,484.00 Ex Tax: Rs.2,484.00
INFECTIOUS MICROBE C by FIRSHEIN - 9780199329618
Of the almost innumerable interactions between science and humanity, few are as central or as signif..
Rs.2,484.00 Ex Tax: Rs.2,484.00
Infinite Vision PB
Rs.499.00 Ex Tax: Rs.499.00
Inflection:Career Arcs From Evolving India
Rs.299.00 Ex Tax: Rs.299.00
Inflection:Career Arcs From Evolving India
Inflection:Career Arcs From Evolving India..
Rs.299.00 Ex Tax: Rs.299.00
Informal Labor, Formal Politics, and Dignified Discontent in India (SOUTH ASIAN EDITION)
Rs.922.50 Ex Tax: Rs.922.50
Informal Labor, Formal Politics, and Dignified Discontent in India (SOUTH ASIAN EDITION)
Informal Labor, Formal Politics, and Dignified Discontent in India (SOUTH ASIAN EDITION)..
Rs.922.50 Ex Tax: Rs.922.50
INFORMATION AND COMMUNICATIONS TECHNOLOGY FOR TEACHERS
Rs.135.00 Ex Tax: Rs.135.00
INFORMATION AND COMMUNICATIONS TECHNOLOGY FOR TEACHERS
INFORMATION AND COMMUNICATIONS TECHNOLOGY FOR TEACHERS..
Rs.135.00 Ex Tax: Rs.135.00
INFORMATION TECHNOLOGY FOR RETAIL by GIRDHAR JOSHI - 9780195697964
Rs.415.00 Ex Tax: Rs.415.00
INFORMATION TECHNOLOGY FOR RETAIL by GIRDHAR JOSHI - 9780195697964
INFORMATION TECHNOLOGY FOR RETAIL,Information Technology for Retail is a concise yet comprehensive b..
Rs.415.00 Ex Tax: Rs.415.00
Information Theory and Coding by Example South Asian Edition
Rs.715.50 Ex Tax: Rs.715.50
Information Theory and Coding by Example South Asian Edition
Information Theory and Coding by Example South Asian Edition..
Rs.715.50 Ex Tax: Rs.715.50
INFOTECH : ENGLISH FOR COMPUTER USERS 3/E : 1ACD
Rs.918.00 Ex Tax: Rs.918.00
INFOTECH : ENGLISH FOR COMPUTER USERS 3/E : 1ACD
INFOTECH : ENGLISH FOR COMPUTER USERS 3/E : 1ACD..
Rs.918.00 Ex Tax: Rs.918.00
INFOTECH. STUDENT`S BOOK 3/E
Rs.1,098.00 Ex Tax: Rs.1,098.00